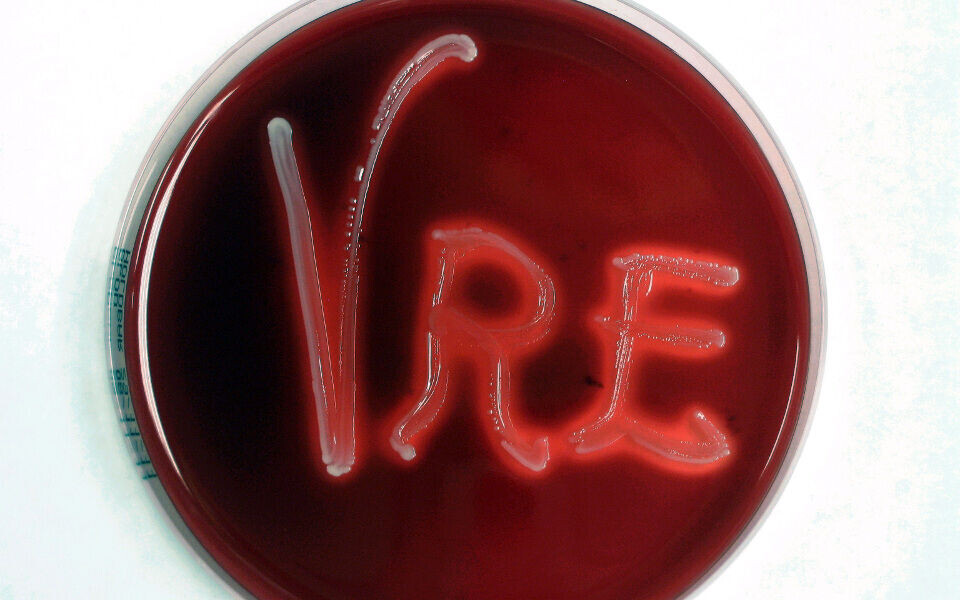

Aktuelt
Det går mot rekordår for VRE i Norge
Ved utgangen av september var det registrert 272 tilfeller med vankomycinresistente enterokokker (VRE) i Norge.
Det viser tall fra Meldingssystemet for smittsomme sykdommer (MSIS).
Bare én gang før, i 2011, har det vært registrert flere tilfeller. Da var det 291 tilfeller av infeksjon eller smittebærertilstand i løpet av et helt år, de fleste var knyttet til et utbrudd på Haukeland universitetssjukehus. Hordaland har siden da ligget høyt på den norske VRE-statistikken, og i fjor og i år har antall tilfeller økt kraftig igjen.
Med 272 tilfeller på ni måneder er det ikke usannsynlig at det totale antallet for hele 2017 vil bli høyere enn i 2011. I år er det registrert VRE i nesten alle landets fylker. Ifølge NRK er det i 2017 meldt om nye sykehusutbrudd både i Oslo, Førde, Stavanger og Kristiansand.
Gunnar Skov Simonsen, leder for NORM - Norsk overvåkingssystem for antibiotikaresistens hos mikrober, sier til NRK at norsk helsepersonell kan bli flinkere med håndhygiene og at det kan bidra til at antibiotikaresistente bakterier som VRE ikke får etablert seg i sykehusene.
Vankomycin-resistente enterokokker i Norge
År | Antall tilfeller |
2008 | 6 |
2009 | 6 |
2010 | 54 |
2011 | 291 |
2012 | 171 |
2013 | 118 |
2014 | 110 |
2015 | 81 |
2016 | 140 |
2017 (jan.–sept.) | 272 |
Kilde: Folkehelseinstituttet / MSIS